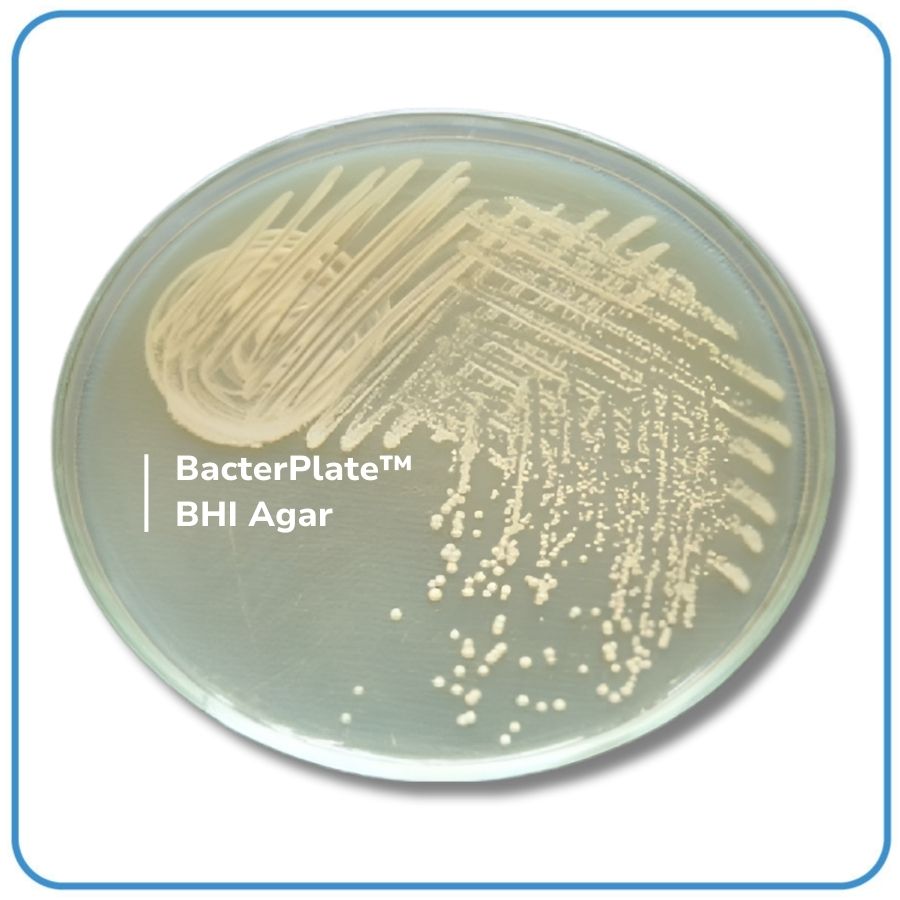

INTENDED USE
- BacterPlate™ BHIAgar is recommended for the cultivation of fastidious pathogenic bacteria, yeasts and moulds from clinical and non clinical samples.
- The packaging with semi-permeable Cellophane film helps balance the humidity of the environment during storage.
PRINCIPLES
- BacterPlate™ BHIAgar The medium contains brain and heart infusions that provide essential nutrients for microbial growth. Peptone and dextrose supply additional nitrogen, carbon, and energy sources. Sodium chloride maintains osmotic balance, while agar serves as the solidifying agent. The rich composition makes it ideal for the growth of a wide variety of organisms, including those that are nutritionally demanding
- Streak the surface of the medium with a bacterial suspension or inoculate directly from the sample. For fungal cultures, use appropriate inoculation techniques.
- Incubate at the temperature and atmospheric conditions appropriate for the organism being cultured (e.g., aerobic, anaerobic, or microaerophilic).
- Typical incubation: 35 – 37°C for 18 – 48 hours for bacteria; up to 7 days for fungal cultures.
RESULTS
- Observe the growth characteristics, including colony morphology, color, and size.
- Perform further biochemical or molecular tests for identification if needed.
BacterLab ensures the quality of each product batch by testing with ATCC reference strains.
| Strains | Incubation Conditions | Culture results |
| S.aureus ATCC 25923 | Incubate at 35 – 37°C for 18 – 24 hours | Good growth |
| E. coli ATCC 35218 | Good growth | |
| C.albicans ATCC 10231 | Good growth |
For 1 liter of medium
| Brain heart extract | 17,5 g |
| Pancreatic digest of gelatin | 10,0 g |
| Sodium chloride | 5,0 g |
| Disodium phosphate | 2,5 g |
| Glucose | 2,0 g |
| Agar | 15,0 g |
pH of the ready-to-use medium at 250C: 7,4 ± 0,2
*Note: This ingredient is for reference only our company will formulate the ingredient according to requests or tender specifications.
| Product Name | Code | Packaging |
| BacterPlate™ BHI Agar | 05054 | 10 plates/ box or as per customer request. |
Related products
BacterPlate™ Bromocresol Purple Agar (BCP)
- Ready-to-use medium on 90mm plates for differentiating between Enterobacteriaceae and Coliforms
- Code: 05032
- Packaging: 10 plates/ box or as per customer request.
- Storage Conditions: 2–8°C.
- Transportation: Ambient temperature.
- Shelf Life: 03 months from the date of manufacture.
BacterChrom™ ESBL Agar Plates
- Ready-to-use chromogenic medium on 90mm plates for detecting gram-negative bacteria producing Extended-Spectrum Beta–Lactamase.
- Code: 01009
- Packaging: 10 plates/box or as per customer requirements.
- Storage Conditions: 2–8°C.
- Transportation: Ambient temperature.
- Shelf Life: 03 months from the date of manufacture.
Categories: Culture media, Ready-to-use 90mm agar plates
BacterChrom™ StrepB Agar Plates
- Ready-to-use chromogenic medium on 90mm plates for isolating and differentiating Streptococcus group B (S. agalactiae).
- Code: 01003
- Packaging: 10 plates/box or as per customer requirements.
- Storage Conditions: 2–8°C.
- Transportation: Ambient temperature.
- Shelf Life: 03 months from the date of manufacture.
Categories: Culture media, Ready-to-use 90mm agar plates, Urine Analysis
BacterChrom™ KPC Agar Plates
- Ready-to-use chromogenic medium on 90mm plates for detection of carbapenem-resistant Enterobacteriaceae (CRE).
- Code: 01007
- Packaging: 10 plates/box or as per customer requirements.
- Storage Conditions: 2–8°C.
- Transportation: Ambient temperature.
- Shelf Life: 03 months from the date of manufacture.
Categories: Culture media, Ready-to-use 90mm agar plates
BacterPlate™ Two-Compartment Medium Edwardsiella/Aeromonas
- Ready-to-use medium on 90mm plates for the detection and differentiation of Edwardsiella ictaluri and Aeromonas hydrophila
- Code: 05052
- Packaging: 10 plates/ box or as per customer request.
- Storage Conditions: 2–8°C.
- Transportation: Ambient temperature.
- Shelf Life: 04 months from the date of manufacture.
Categories: Culture media, Ready-to-use 90mm agar plates
BacterPlate™ Sabouraud Dextrose Agar (SDA)
- Ready-to-use medium on 90mm plates for culturing, differentiating, and quantifying yeasts and molds.
- Code: 05027
- Packaging: 10 plates/ box or as per customer request.
- Storage Conditions: 2–8°C.
- Transportation: Ambient temperature.
- Shelf Life: 04 months from the date of manufacture.
BacterPlate™ Nutrient Agar (NA)
- Ready-to-use medium on 90mm plates is a basic nutrient-rich medium for cultivating easily cultured bacteria.
- Code: 05023
- Packaging: 10 plates/ box or as per customer request.
- Storage Conditions: 2–8°C.
- Transportation: Ambient temperature.
- Shelf Life: 04 months from the date of manufacture.
BacterPlate™ Chocolate Agar with VTAP (HP VTAP)
- Ready-to-use medium on 90mm plates supplemented with VTAP for the selective culture of Helicobacter pylori
- Code: 05011
- Packaging: 10 plates/ box or as per customer request.
- Storage Conditions: 2–8°C.
- Transportation: Ambient temperature.
- Shelf Life: 04 months from the date of manufacture.
Categories: Culture media, Ready-to-use 90mm agar plates
BacterPlate™ Pylori Agar
- Ready-to-use medium on 90mm plates for culturing and screening Helicobacter pylori in gastric biopsy samples.
- Code: 05058
- Packaging: 10 plates/ box or as per customer request.
- Storage Conditions: 2–8°C.
- Transportation: Ambient temperature.
- Shelf Life: 03 months from the date of manufacture.
Categories: Culture media, Ready-to-use 90mm agar plates
BacterPlate™ Two-Compartment Medium ESBL/KPC
- Ready-to-use medium on 90mm plates for the detection and differentiation of ESBL producing bacteria and Carbapenemase-producing bacteria (KPC)
- Code: 05051
- Packaging: 10 plates/ box or as per customer request.
- Storage Conditions: 2–8°C.
- Transportation: Ambient temperature.
- Shelf Life: 04 months from the date of manufacture.
Categories: Culture media, Ready-to-use 90mm agar plates


 Vn
Vn